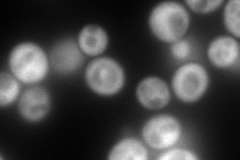
YDL160C
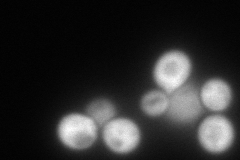
YDL160C
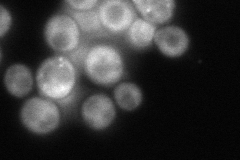
YDL160C
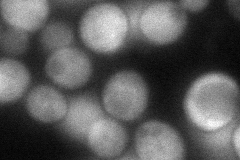
YDL160C
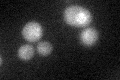
YDL160C
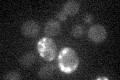
YDL160C

View description
Cytoplasmic DExD/H-box helicase, stimulates mRNA decapping, coordinates distinct steps in mRNA function and decay, interacts with both the decapping and deadenylase complexes, may have a role in mRNA export and translation
Localization:
Intensity:
Fold change:
Significance:
-
C’ GFP library in SD

below threshold14.38 -
N' NOP1pr-GFP in SD
cytosol353.063 -
N' TEF2pr-mCherry in SD
cytosol287.551 -
N' NATIVEpr-GFP in SD
cytosol139.442 -
N' TEF2pr-VC and Cyto-VN in SD
cytosol86.5817 -
C’ GFP library in SD+DTT
cytosol14.981.04No -
C’ GFP library in SD+H2O2

cytosol16.111.12No -
C’ GFP library in Starvation Media
cytosol15.631.08No -
C’ GFP library on the background of Pup2-DaMP

below threshold -
C’ GFP library on the background of CCT mutant

below threshold16.47691.14522No
